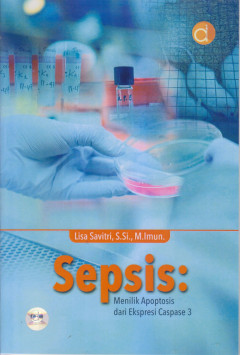
cover

Ditapis dengan

Pengenalan Sistem Pendukung Keputusan
Buku ini merupakan buku ajar yang disusun untuk kalangan mahasiswa Jurusan Komputer yang ingin memahami dan mengenal sistem pendukung keputusan. Buku ini disusun secara sistematis dan menyesuaikan kebutuhan pembaca yang ingin memahami sistem pendukung keputusan secara cepat dan cermat. Pembaca akan diberikan teori atau pengertian setiap bab, cara perhitungan, dan contoh kasus yang dibahas secar…
- Edisi
- 1
- ISBN/ISSN
- 9786230219856
- Deskripsi Fisik
- xiv, 58 halaman : ilustrasi ; 25 cm
- Judul Seri
- -
- No. Panggil
- 658.403 FER p

Analisis Rasionalitas Antibiotik di Fasilitas Pelayanan Kesehatan
- Edisi
- 1
- ISBN/ISSN
- 978-623-02-3706-5
- Deskripsi Fisik
- xii,108 hlm, 15.5x23 cm
- Judul Seri
- -
- No. Panggil
- 615.213 SUN a
- Edisi
- 1
- ISBN/ISSN
- 978-623-02-3706-5
- Deskripsi Fisik
- xii,108 hlm, 15.5x23 cm
- Judul Seri
- -
- No. Panggil
- 615.213 SUN a

Karakterisasi Sediaan Cair Farmasi
Buku karakterisasi sedian cari farmasi merupakan buku seri lanjutan dari karakterisasi sediaan padat farmasi. Buku ini selain menjadi buku ajar dari mata kuliah Farmasi Fisika untuk tingkat Sarjana Farmasi, juyga bisa digunakan sebagai dasar dalam mendesain sediaan cair farmasi karena berisi materi gambaran karakterisasi sediaan cair farmasi beserta evaluasinya. Dalam edisi ini dibahas dengan d…
- Edisi
- Ed.1
- ISBN/ISSN
- 978-602-475-318-4
- Deskripsi Fisik
- -
- Judul Seri
- -
- No. Panggil
- 610.153 NAS k

Buku Ajar Analisis Kualitas Lingkungan
Sinopsis: Ilmu Lingkungan dan Kesehatan Masyarakat Ilmu lingkungan adalah penerapan prinsip-prinsip ekologi dalam kehidupan manusia untuk menjaga keseimbangan alam. Pendekatan yang digunakan mencakup berbagai metode, seperti: Pendekatan Holistik Pendekatan Evolusioner Pendekatan Interaktif Pendekatan Situasional Pendekatan Sosiosistem dan Ekosistem Pendekatan Peranan dan Perilaku Man…
- Edisi
- Ed.1
- ISBN/ISSN
- 9786230221200
- Deskripsi Fisik
- viii, 33 hlm.; 15,5 x 23 cm.
- Judul Seri
- -
- No. Panggil
- 613.1 NOR b

Mengenal Karakter Molekuler dan Imunogenesitas Flagella Salmonella typhi Peny…
Monograf ini mengupas tuntas teori, konsep, metode praktis di laboratorium, serta hasil penelitian terkait profil protein flagellin dan gen flagellin dari Salmonella typhi isolat Jawa Tengah dan Yogyakarta, termasuk imunogenesitasnya. Imunogenesitas protein flagellin mencakup kemampuannya dalam memicu respons imun, seperti: Produksi nitric oxide (NO). Aktivitas fagositosis makrofag. Ind…
- Edisi
- Cet. 1
- ISBN/ISSN
- 9786230228582
- Deskripsi Fisik
- xii, 59 hlm.; 14 x 20 cm.
- Judul Seri
- -
- No. Panggil
- 616.92 SRI m

Sepsis : Menilik Apoptosis dari Ekspresi Caspase 3
- Edisi
- 1
- ISBN/ISSN
- 978-623-02-5818-3
- Deskripsi Fisik
- -
- Judul Seri
- -
- No. Panggil
- 616.3 LIS s
- Edisi
- 1
- ISBN/ISSN
- 978-623-02-5818-3
- Deskripsi Fisik
- -
- Judul Seri
- -
- No. Panggil
- 616.3 LIS s

Manajemen Farmasi & Alat Kesehatan
Saat ini apotek memang bisa dijadikan sebagai lahan bisnis yang sangat menggiurkan, mengingat kesehatan merupakan salah satu kebutuhan masyarakat, sehingga permintaan obat dari tahun ke tahun semakin meningkat. Dalam satu daerah saja, sudah banyak berdiri apotek dengan fasilitas lengkap, termasuk dokter jaga dan ruang praktik. Secara umum, apotek mempunyai dua fungsi, yaitu memberikan layanan k…
- Edisi
- Ed.1
- ISBN/ISSN
- 978-602-376-826-4
- Deskripsi Fisik
- vi + 158 hlm
- Judul Seri
- -
- No. Panggil
- 615 TAT m

Pengantar Fisika Kedokteran
- Edisi
- ed.1
- ISBN/ISSN
- 978-623-359-132-4
- Deskripsi Fisik
- 15,5x23cm; xx + 322 hlm
- Judul Seri
- -
- No. Panggil
- 610.155 BAM p
- Edisi
- ed.1
- ISBN/ISSN
- 978-623-359-132-4
- Deskripsi Fisik
- 15,5x23cm; xx + 322 hlm
- Judul Seri
- -
- No. Panggil
- 610.155 BAM p

Buku Panduan Kanker Payudara Untuk Awam
- Edisi
- 1
- ISBN/ISSN
- 978-602-514-058-7
- Deskripsi Fisik
- -
- Judul Seri
- -
- No. Panggil
- 616.128 SOE b
- Edisi
- 1
- ISBN/ISSN
- 978-602-514-058-7
- Deskripsi Fisik
- -
- Judul Seri
- -
- No. Panggil
- 616.128 SOE b
Dari Diabetes Menuju Jantung & Stroke
Diabetes dikenal sebagai gangguan kesehatan yang rentan dapat mengundang penyakit lain, salah satunya adalah jantung dan stroke. Penyakit diabetes terjadi karena kadar gula dalam tubuh meningkat sehingga dapat menyebabkan komplikasi yang menimbulkan beragam penyakit. Penyebab kematian terbesar di dunia adalah penyakit jantung dan pembuluh darah otak (kardio-serebro-vaskular). Lebih dari 50% …
- Edisi
- 1
- ISBN/ISSN
- 9786020614106
- Deskripsi Fisik
- -
- Judul Seri
- -
- No. Panggil
- 616.66 HAN d
 Karya Umum
Karya Umum  Filsafat
Filsafat  Agama
Agama  Ilmu-ilmu Sosial
Ilmu-ilmu Sosial  Bahasa
Bahasa  Ilmu-ilmu Murni
Ilmu-ilmu Murni  Ilmu-ilmu Terapan
Ilmu-ilmu Terapan  Kesenian, Hiburan, dan Olahraga
Kesenian, Hiburan, dan Olahraga  Kesusastraan
Kesusastraan  Geografi dan Sejarah
Geografi dan Sejarah